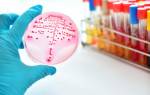

Особенности действия
Препараты Кардиомагнил и Фазостабил изготавливаются на основе ацетилсалициловой кислоты и гидроксида магния. Содержание активного вещества в таблетках с пленочной оболочкой одинаково для обоих медикаментов: 75 и 15,2 мг соответственно. Также доступны таблетки с дозировкой 150 и 30,39 мг.
Механизм действия этих препаратов основан на том, что аспирин (ацетилсалициловая кислота) замедляет синтез простагландинов и предотвращает образование тромбоксана. Влияние Кардиомагнила и Фазостабила на тромбоциты длится дольше, чем время нахождения ацетилсалициловой кислоты в организме, и прекращается только после формирования новых тромбоцитов.
Эти средства обладают антиагрегантным, противовоспалительным, жаропонижающим и анальгезирующим эффектами. После попадания в организм они быстро всасываются в желудке и кишечнике.
Врачи часто обсуждают эффективность и безопасность препаратов для профилактики сердечно-сосудистых заболеваний. Фазостабил и Кардиомагнил имеют свои преимущества и недостатки. Фазостабил, обладая уникальным механизмом действия, направлен на улучшение микроциркуляции и снижение вязкости крови, что может быть полезно при различных сердечно-сосудистых патологиях. В то же время, Кардиомагнил, содержащий ацетилсалициловую кислоту и магний, широко используется для предотвращения тромбообразования и снижения риска инфарктов и инсультов. Врачи отмечают, что выбор между этими препаратами зависит от индивидуальных показаний пациента, его состояния здоровья и наличия сопутствующих заболеваний. Поэтому важно, чтобы решение принималось совместно с лечащим врачом, который сможет учесть все нюансы и подобрать наиболее подходящий вариант.

Показания
Список показаний для назначения Фазостабила и Кардиомагнила одинаковый.
| Свойство | Фазостабил | Кардиомагнил |
|---|---|---|
| Действующее вещество | Ацетилсалициловая кислота (АСК) | Ацетилсалициловая кислота (АСК) + Магния гидроксид |
| Дозировка АСК | Различна, в зависимости от препарата | Различна, в зависимости от препарата |
| Основное действие | Противовоспалительное, жаропонижающее, анальгезирующее, антиагрегантное | Противовоспалительное, жаропонижающее, анальгезирующее, антиагрегантное, антацидное |
| Защита желудка | Нет | Частичная, за счет магния гидроксида |
| Риск побочных эффектов со стороны ЖКТ | Высокий | Сниженный по сравнению с чистой АСК |
| Показания к применению | Профилактика и лечение сердечно-сосудистых заболеваний, головная боль, лихорадка, воспалительные процессы | Профилактика и лечение сердечно-сосудистых заболеваний, головная боль, лихорадка, воспалительные процессы, изжога, диспепсия |
| Цена | Обычно ниже | Обычно выше |
Их выписывают в случаях, когда требуется:
- первичная профилактика сердечно-сосудистых заболеваний у пациентов группы риска;
- снижение вероятности повторного инфаркта или тромбообразования в сосудах;
- улучшение состояния пациентов с нестабильной стенокардией.
Мнения людей о Фазостабиле и Кардиомагниле разделяются. Многие пациенты отмечают, что Фазостабил помогает им лучше справляться с проблемами, связанными с сердечно-сосудистой системой. Они подчеркивают его эффективность в снижении уровня холестерина и улучшении общего самочувствия. Однако некоторые пользователи отмечают, что у них возникали побочные эффекты, такие как головные боли или расстройства пищеварения.
С другой стороны, Кардиомагнил пользуется популярностью благодаря своей доступности и хорошей переносимости. Люди, принимающие этот препарат, часто говорят о его положительном влиянии на профилактику сердечно-сосудистых заболеваний. Тем не менее, некоторые пациенты выражают недовольство по поводу длительности курса лечения и необходимости регулярного контроля состояния здоровья.
В конечном итоге, выбор между Фазостабилом и Кардиомагнилом зависит от индивидуальных особенностей организма и рекомендаций врача. Каждый случай уникален, и важно учитывать личные ощущения и результаты лечения.

Медикаменты с целью первичной профилактики требуются людям, у которых:
- артериальная гипертензия;
- неблагоприятная наследственность (если у родителей, братьев или сестер были инфаркты до 55 лет);
- повышенный уровень холестерина;
- диабет;
- избыточная масса тела (индекс массы тела выше 30).
Кардиомагнил рекомендуется при ишемической болезни сердца как в хронической, так и в острой формах. В отличие от Кардиомагнила, Фазостабил назначается после сосудистых операций для предотвращения тромбоэмболии.
Способ использования
Дозировка препаратов подбирается индивидуально для каждого пациента, в зависимости от его показаний и состояния здоровья. Совместное применение Кардиомагнила и Фазостабила нецелесообразно, так как эти препараты имеют схожий состав. Такая комбинация может привести к передозировке и повышению уровня солей лития и барбитуратов в крови.
При ишемической болезни сердца и для снижения риска повторного образования тромбов рекомендуется начинать с дозы 150 мг в сутки. На второй день дозировка уменьшается до 75 мг.
Пациентам с нестабильной стенокардией и тем, кто перенес острый инфаркт миокарда, необходимо принимать 150 мг. Лечение следует начинать немедленно после появления первых симптомов.
Для первичной профилактики тромбообразования достаточно одной таблетки в день по 75 мг любого из указанных препаратов. Совместное употребление Кардиомагнила и Фазостабила не рекомендуется; лучше выбрать одно из этих средств.

Противопоказания
Кардиомагнил и Фазостабил не назначаются при следующих условиях:
- аллергии на аспирин и другие нестероидные противовоспалительные средства;
- перенесенных мозговых кровоизлияниях;
- язвенно-эрозивных заболеваниях желудочно-кишечного тракта;
- бронхиальной астме, вызванной салицилатами;
- тяжелой почечной или печеночной недостаточности;
- хронической сердечной недостаточности;
- беременности (в первом и третьем триместрах).
При этих состояниях не рекомендуется назначать препараты с ацетилсалициловой кислотой. Эти лекарства не предназначены для детей и могут быть назначены только лицам старше 18 лет.
Сравнительная характеристика
Согласно инструкциям по применению Кардиомагнила и Фазостабила, их механизмы действия, состав основных компонентов, возможные побочные эффекты и противопоказания идентичны. Вероятность осложнений при использовании обоих препаратов также сопоставима.
Кардиомагнил производится немецкой компанией Такеда ГмбХ, а Фазостабил — российским производителем ОЗОН. Сравнить эти препараты можно с помощью анализов, которые покажут их влияние на систему свертывания крови. Многие пациенты предпочитают немецкий препарат.
Врачи не проводят экспериментальные сравнения, а назначают лекарства на основе аспирина и магния гидроксида. Они могут подробно рассказать о достоинствах и недостатках как Кардиомагнила, так и Фазостабила.
Упаковка Кардиомагнила, содержащая 100 таблеток по 75+15,2 мг, стоит около 260 рублей. Аналогичное количество таблеток Фазостабила в пленочной оболочке 75+15,2 мг обойдется в 154 рубля.
Судя по отзывам, эффективность этих препаратов и реакция организма на их применение схожи. Если пациент хорошо переносит Кардиомагнил, переход на более доступный Фазостабил не вызовет проблем.
Подбор аналогов
Для предотвращения тромбообразования специалисты могут рекомендовать не только российский Фазостабил или немецкий Кардиомагнил, но и множество других препаратов. Одним из аналогов Фазостабила и Кардиомагнила является ТромбоМаг, выпускаемый компанией ООО «Хемофарм», который содержит аспирин и гидроксид магния.
Если потребуется, врач может предложить и другие варианты. В качестве альтернативы могут быть назначены:
- Аспирин Кардио;
- Ацекардол;
- Зилт;
- Тромбо АСС;
- Клопидогрел.
Однако не следует самостоятельно изменять назначенное лечение без консультации с врачом. Медицинские специалисты также не рекомендуют начинать прием других препаратов одновременно с Кардиомагнилом без предварительной оценки. При выборе стратегии лечения врач учитывает взаимодействие лекарств, возможные побочные эффекты и противопоказания. Например, сочетание с антикоагулянтами, другими антиагрегантами и тромболитиками может повысить риск кровотечений.
Вопрос-ответ
Кому нельзя принимать фазостабил?
Препарат Фазостабил противопоказан пациентам с тяжелым нарушением функции почек. Следует с осторожностью применять препарат Фазостабил у пациентов с нарушением функции почек, поскольку ацетилсалициловая кислота может повышать риск развития почечной недостаточности и острой почечной недостаточности.
Как правильно принимать Фазостабил для разжижения крови?
Режим дозирования препарата Фазостабил: принимают внутрь, через 1-2 ч после еды, по 1 разовой дозе 1 раз в сутки. Данная комбинация предназначена для длительного применения. Продолжительность лечения определяется врачом. Особенности действия препарата при первом приеме или отмене препарата не наблюдались.
Что лучше разжижает кровь кардиомагнил или аспирин кардио?
Кардиомагнил может быть рекомендован пациентам с повышенным риском желудочно-кишечных заболеваний, так как в его состав входит гидроксид магния. Аспирин Кардио подойдёт тем, кому важно, чтобы препарат высвобождался не в желудке, а в кишечнике.
Советы
СОВЕТ №1
Перед выбором между Фазостабилом и Кардиомагнилом обязательно проконсультируйтесь с врачом. Специалист поможет определить, какой препарат лучше подходит для вашего состояния здоровья и индивидуальных потребностей.
СОВЕТ №2
Обратите внимание на состав и механизм действия каждого препарата. Фазостабил и Кардиомагнил имеют разные активные вещества и показания, поэтому важно понимать, как они влияют на организм.
СОВЕТ №3
Изучите отзывы других пациентов и результаты клинических исследований. Это поможет вам получить представление о том, как препараты работают на практике и какие побочные эффекты могут возникнуть.
СОВЕТ №4
Не забывайте о важности комплексного подхода к лечению. Препараты могут быть лишь частью вашей терапии, поэтому следите за своим образом жизни, питанием и физической активностью для достижения наилучших результатов.